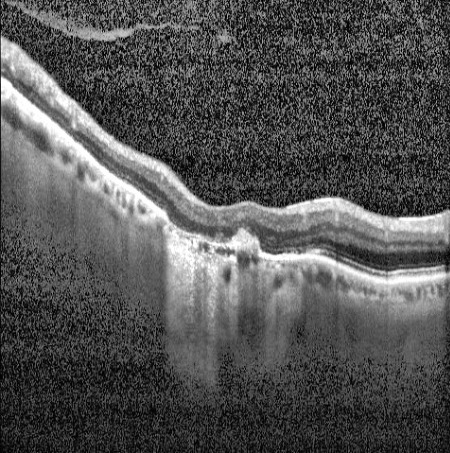
OCT cross-sectional scan showing retinal layers and foveal structure

How RetGuard Works
From image capture to clinical report in under 30 seconds. Follow the three steps of a RetGuard screening.
Two imaging modalities. One device.
The RetGuard camera captures both fundus photographs and OCT scans — the two gold-standard imaging methods for retinal screening — giving the AI a complete picture of the retina.

Five conditions. One simultaneous analysis.
RetGuard's AI analyzes the captured images and screens for all five conditions at once — in under 30 seconds, entirely on-device, with no data leaving the clinic.
Diabetic Retinopathy
Diabetic Macular Edema
Glaucoma
Age-Related Macular Degeneration
Hypertensive Retinopathy
All five conditions are screened from a single capture session. Results include calibrated confidence scores and referral recommendations for each condition independently.
Every result comes with visual evidence
RetGuard generates visual heatmaps that highlight the exact retinal regions that influenced each screening result — so clinicians can see what the AI found and where.
When Hypertensive Retinopathy is detected, the report automatically recommends relevant laboratory tests — bridging retinal findings with systemic evaluation.